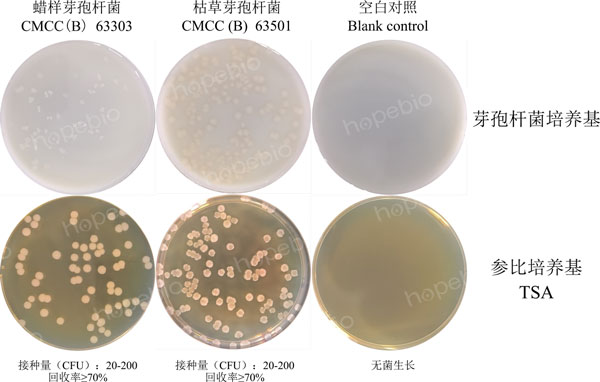
图1 芽孢杆菌培养基的微生物质控结果

海博微信公众号
海博微信公众号
 海博天猫旗舰店
海博天猫旗舰店


 海博微信公众号
海博微信公众号
 海博天猫旗舰店
海博天猫旗舰店




一、试验原理与介绍
芽孢杆菌属细菌较大(4μm ~10μm),革兰氏阳性菌,是严格需氧或兼性厌氧的有荚膜的杆菌。芽孢杆菌属可分为以下亚群:多黏芽孢杆菌、枯草芽孢杆菌(包括蜡样芽孢杆菌和地衣芽孢杆菌)、短芽孢杆菌和炭疽芽孢杆菌。
本培养基用于芽孢杆菌平板计数,葡萄糖为细菌生长提供碳源;氯化钾可以维持培养基均衡的渗透压;酵母提取物、硫酸铵为细菌生长提供氮源;磷酸钙有利于促进细菌芽孢的快速生成,硫酸锰、七水硫酸镁、硫酸亚铁提供细菌菌体生长以及芽孢生成所需的微量元素。
二、培养基配方(g/L)
|
葡萄糖 |
10.0 |
|
磷酸钙 |
5.0 |
|
硫酸铵 |
0.5 |
|
氯化钾 |
0.2 |
|
七水硫酸镁 |
0.1 |
|
硫酸锰 |
0.0001 |
|
硫酸亚铁 |
0.0001 |
|
酵母提取物 |
0.5 |
|
琼脂 |
20.0 |
|
pH 7.0±0.2(25℃) |
|
三、试验方法
1、称取本品36.3g,加热溶解于1000mL蒸馏水中,分装,121℃高压灭菌30分钟备用。
2、制备菌种悬液,接种至芽孢杆菌培养基上。
3、放置于36℃±1℃恒温培养箱中,需氧培养48h-72h。
四、质控要求
接种以下质控菌株,放置36℃±1℃恒温培养箱中,需氧培养48h-72h。菌株培养结果见图1。
|
质控菌株 |
菌株编号 |
接种量(CFU) |
回收率 |
生长情况 |
其他特征 |
|
蜡样芽孢杆菌 |
CMCC(B) 63303 |
20-200 |
≥70% |
+++ |
白色小菌落 |
|
枯草芽孢杆菌 |
CMCC(B) 63501 |
20-200 |
≥70% |
+++ |
白色小菌落 |
图1 芽孢杆菌培养基的微生物质控结果
五、注意事项
1、该培养基中含不溶性磷酸钙,高压灭菌后存在白色沉淀,倒平板前需充分摇匀培养基,重悬磷酸钙均匀分布于培养基中,再进行倒平板操作,以免造成平板白色背景不均匀,影响试验结果。
2、该培养基倒板后平板整体呈白色,在试验完毕读取菌数时可能发生不易辨别计数的情况,可采用置于灯检箱或打光等方式进行辅助读数。
3、芽孢杆菌在挑菌置于稀释液中振荡分散的过程中,菌苔不易散开,不易形成均匀态菌悬液,这可能导致后续稀释涂布结果菌数不稳定或涂布菌数不易掌握,可以通过缩小相邻稀释度的稀释倍数,进行多梯度稀释度涂布,设立多组平行对照等方式,得到所需的涂布菌数范围,保证试验的有效性。
相关产品:
注:本文属海博生物原创,未经允许不得转载。
下一篇:胆盐乳糖增菌液原理及使用方法



